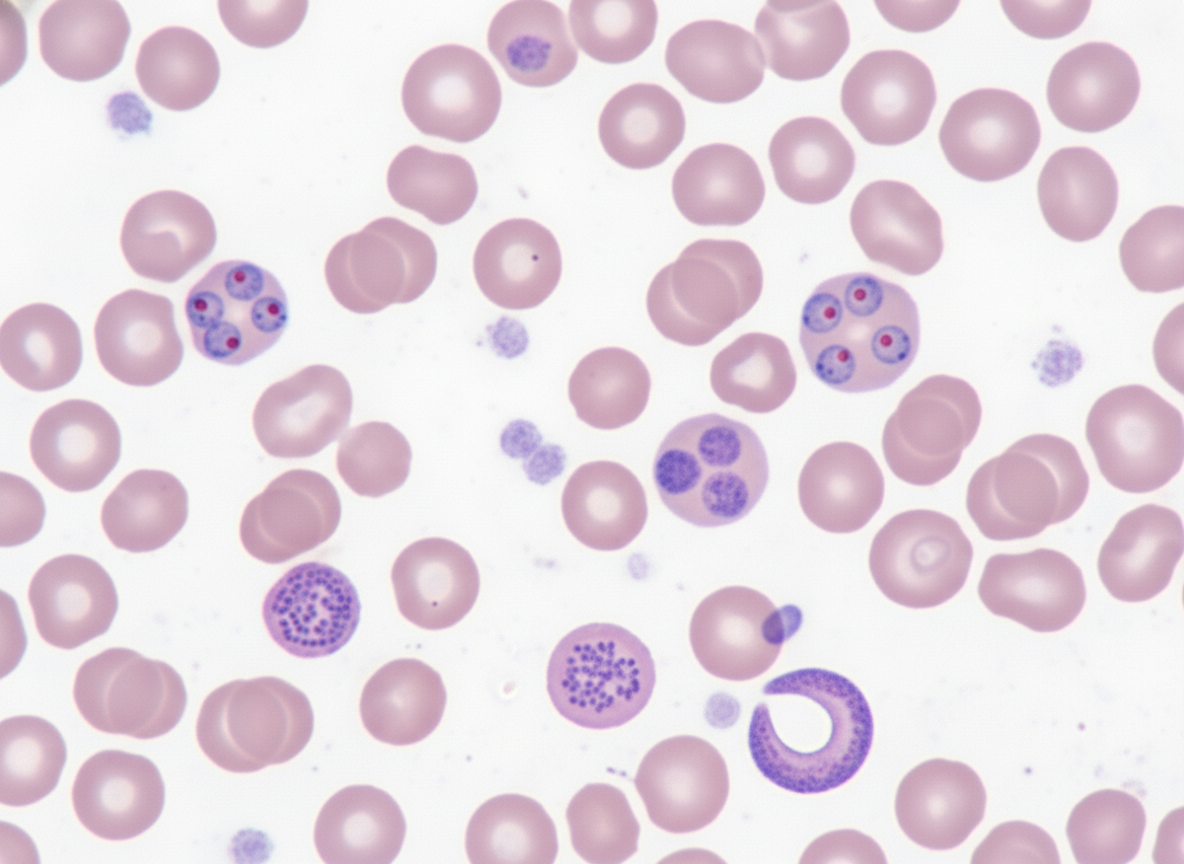
Image for question 34

What parasite is associated with the appearance of rice grains in the stool due to the passage of proglottids?
Banana shaped gametocytes in peripheral smear are characteristic of which Plasmodium species?
Larvae of which of the following parasites reside in muscle tissue?
The following Peripheral Smear shows the presence of?
Profuse watery diarrhea in an immunocompromised child is due to which pathogen?
Which statement is false regarding Wuchereria bancrofti?
Which organism causes fulminant amoebic meningoencephalitis?
All of the following are true about amebic liver abscess except?
Which parasite causes lung cysts?
What investigation is used for the definitive identification of Cryptosporidium?
Explanation: **Explanation:** The correct answer is **Taenia saginata** (Beef Tapeworm). The hallmark clinical feature of *T. saginata* infection is the active migration of gravid proglottids through the anal sphincter. These proglottids are muscular, motile, and white, often described by patients as **"rice grains"** or "white ribbons" moving in the stool or found on undergarments. **Why Taenia saginata is correct:** Unlike other tapeworms, the proglottids of *T. saginata* are highly motile. A single gravid proglottid contains approximately 100,000 eggs and has 15–30 lateral uterine branches (a key diagnostic feature). Their independent motility allows them to crawl out of the anus, leading to the "rice grain" appearance. **Why other options are incorrect:** * **Taenia solium:** While it also sheds proglottids, they are less motile than *T. saginata* and have fewer lateral uterine branches (7–13). The primary clinical concern with *T. solium* is Cysticercosis. * **Diphyllobothrium latum:** This worm releases eggs through a uterine pore rather than shedding intact gravid proglottids. It is clinically associated with Vitamin B12 deficiency (Megaloblastic anemia). * **Hymenolepis nana:** This is the smallest tapeworm. The proglottids are tiny and usually disintegrate in the gastrointestinal tract before being passed, so they are not typically seen as "rice grains." **NEET-PG High-Yield Pearls:** * **Diagnostic Morphological Feature:** *T. saginata* has a scolex with 4 suckers but **no rostellum or hooks** (unarmed), whereas *T. solium* has both (armed). * **Intermediate Host:** Cow/Beef (*T. saginata*); Pig/Pork (*T. solium*). * **Treatment of Choice:** Praziquantel is the drug of choice for the intestinal stage of both species.
Explanation: **Explanation:** The correct answer is **Plasmodium falciparum**. **1. Why Plasmodium falciparum is correct:** In the life cycle of *P. falciparum*, the gametocytes (sexual stages) undergo a unique maturation process in the bone marrow and spleen. By the time they appear in the peripheral blood (Stage V), they have transitioned from a round shape to a distinctive **crescentic, sickle, or banana shape**. These gametocytes contain centrally clustered malaria pigment (hemozoin) and are a hallmark diagnostic feature in peripheral blood smears. **2. Why the other options are incorrect:** * **P. vivax:** Gametocytes are typically **round or oval** and fill almost the entire enlarged erythrocyte. The presence of Schüffner’s dots is common. * **P. malariae:** Gametocytes are **round to oval** and smaller than those of *P. vivax*. They do not enlarge the red blood cell. * **P. ovale:** Similar to *P. vivax*, the gametocytes are **round or oval**, but the host erythrocyte often appears fimbriated (jagged edges) and oval-shaped. **3. NEET-PG High-Yield Pearls:** * **Multiple rings per RBC** and **Maurer’s dots** are also characteristic of *P. falciparum*. * *P. falciparum* is the only species where typically **only** ring forms and gametocytes are seen in peripheral smears (mature trophozoites and schizonts are sequestered in deep capillaries). * **Recrudescence** is seen in *P. falciparum* (due to inadequate treatment), whereas **Relapse** is seen in *P. vivax/ovale* (due to hypnozoites in the liver). * *P. falciparum* causes **Blackwater Fever** (massive intravascular hemolysis and hemoglobinuria).
Explanation: **Explanation:** The correct answer is **Trichinella spiralis**. This parasite is unique among nematodes because it completes its entire life cycle (adults and larvae) within a single host. After ingestion of undercooked meat (usually pork) containing encysted larvae, the larvae mature into adults in the small intestine. The female then releases newborn larvae that enter the bloodstream and selectively migrate to **striated skeletal muscles** (especially active muscles like the diaphragm, tongue, and deltoid). Here, they encyst within muscle cells, transforming them into "nurse cells." **Why the other options are incorrect:** * **Ascaris lumbricoides (Roundworm):** The larvae undergo a heart-lung migration (Loeffler’s syndrome) but eventually reside as adults in the **small intestine**. They do not encyst in muscle. * **Hookworm (Ancylostoma/Necator):** Larvae penetrate the skin and migrate through the lungs to reach the **small intestine**, where they attach to the mucosa to suck blood. * **Pinworm (Enterobius vermicularis):** This parasite has no tissue migration phase. The entire life cycle occurs within the **gastrointestinal tract**, with females migrating to the perianal skin to lay eggs. **High-Yield NEET-PG Pearls:** * **Clinical Triad of Trichinellosis:** Myalgia (muscle pain), periorbital edema, and eosinophilia. * **Diagnosis:** Muscle biopsy (showing coiled larvae) or the **Bachman intradermal test**. * **Dead-end Host:** Humans are considered dead-end hosts because the larvae encysted in our muscles are unlikely to be ingested by another host. * **Drug of Choice:** Albendazole or Mebendazole.
Explanation: ***Gametocyte*** - The **crescent** or **banana-shaped** structure seen in peripheral blood smear is characteristic of **Plasmodium falciparum gametocytes**. - Gametocytes are the **sexual forms** of the malaria parasite responsible for **transmission** to mosquitoes and are diagnostic of malaria infection. *Sporozoite* - Sporozoites are the **infective forms** found in mosquito salivary glands and are **not visible** in peripheral blood smears. - They rapidly migrate to the **liver** within minutes of mosquito bite and cannot be detected in routine blood examination. *Merozoite* - Merozoites are **briefly present** in blood after liver schizont rupture but appear as **ring forms** when they invade RBCs. - They do not have the characteristic **crescent shape** and are typically seen as small ring-like structures within red blood cells. *Schistocyte* - Schistocytes are **fragmented red blood cells** with irregular shapes, not parasitic forms. - They indicate **microangiopathic hemolytic anemia** and lack the organized crescent structure of malarial gametocytes.
Explanation: **Explanation:** **Cryptosporidium hominis/parvum** is the most common cause of severe, life-threatening, profuse watery diarrhea in immunocompromised individuals, particularly those with HIV/AIDS (CD4 count <200 cells/mm³) or children with primary immunodeficiencies. The parasite infects the intestinal epithelium, causing malabsorption and electrolyte imbalance. While it causes self-limiting diarrhea in healthy individuals, it leads to chronic, cholera-like diarrhea in the immunocompromised. **Analysis of Incorrect Options:** * **Amoeba (Entamoeba histolytica):** Typically presents as **amoebic dysentery** (bloody stools with mucus) and tenesmus, rather than profuse watery diarrhea. It is characterized by flask-shaped ulcers in the colon. * **Giardia lamblia:** Causes **steatorrhea** (foul-smelling, greasy stools that float) and bloating. It is more common in children but does not typically cause the massive fluid loss seen with Cryptosporidium. * **Lactose Intolerance:** This is a non-infectious condition resulting from lactase deficiency. While it causes osmotic diarrhea, it is usually triggered by dairy intake and is not specifically associated with an immunocompromised state. **High-Yield Clinical Pearls for NEET-PG:** * **Diagnosis:** Modified Acid-Fast Staining (Kinyoun stain) reveals **bright red, spherical oocysts** (4–6 µm). * **Transmission:** Fecal-oral route; notably **chlorine-resistant**, making it a common cause of swimming pool-associated outbreaks. * **Treatment:** Nitazoxanide is the drug of choice in immunocompetent patients; however, in HIV patients, the primary treatment is **HAART** to restore immune function. * **Other Coccidian Parasites:** *Isospora belli* (larger, elliptical oocysts) and *Cyclospora* (larger, spherical oocysts) also cause similar diarrhea in AIDS patients.
Explanation: **Explanation:** The statement **"Man and Anopheles are hosts"** is considered the false (and thus correct) option because it is incomplete and misleading regarding the primary vectors of *Wuchereria bancrofti*. 1. **Why Option D is False:** While *Anopheles* can transmit the parasite in certain regions, the **most common global vector** for *W. bancrofti* is the **Culex mosquito** (specifically *Culex quinquefasciatus* in urban areas). Furthermore, the life cycle involves two hosts: **Man (Definitive host)** and **Mosquito (Intermediate host)**. The question implies a restricted vector range, whereas *Aedes* and *Mansonia* can also serve as vectors depending on geography. 2. **Analysis of Other Options:** * **Option A (Causes filariasis):** True. It is the primary causative agent of Lymphatic Filariasis (Elephantiasis). * **Option B (Body is long and slender):** True. Adult worms are hair-like, filiform, and creamy white. * **Option C (Terminal nuclei are absent):** True. This is a crucial morphological feature used to differentiate microfilariae under a microscope. In *W. bancrofti*, the nuclei do not extend to the tip of the tail (the tail tip is "empty"), unlike *Brugia malayi*, which has two distinct terminal nuclei. **High-Yield Clinical Pearls for NEET-PG:** * **Nocturnal Periodicity:** Microfilariae appear in peripheral blood primarily between **10 PM and 2 AM** (matching the biting habits of *Culex*). * **Diagnostic Gold Standard:** Detection of microfilariae in a **peripheral blood smear** (thick film) collected at night. * **Drug of Choice:** **Diethylcarbamazine (DEC)**. Note: DEC is contraindicated in Onchocerciasis due to the Mazzotti reaction. * **Tropical Pulmonary Eosinophilia (TPE):** A hypersensitivity reaction to filarial antigens characterized by nocturnal cough, wheezing, and high eosinophil counts.
Explanation: **Explanation:** **Naegleria fowleri** is the correct answer because it is the causative agent of **Primary Amoebic Meningoencephalitis (PAM)**, a rapidly progressive and typically fatal (fulminant) infection of the central nervous system. It is a free-living amoeba found in warm freshwater. Infection occurs when contaminated water is inhaled through the nose, allowing the organism to penetrate the cribriform plate and migrate via the olfactory nerves to the brain. **Analysis of Incorrect Options:** * **Acanthamoeba:** Causes **Granulomatous Amoebic Encephalitis (GAE)**, which is a chronic, subacute infection usually seen in immunocompromised individuals. It also causes amoebic keratitis (associated with contact lens use). * **Entamoeba histolytica:** Primarily causes intestinal amoebiasis and liver abscesses. While it can rarely spread hematogenously to the brain causing a cerebral abscess, it does not cause primary meningoencephalitis. * **Escherichia coli:** A common cause of bacterial meningitis in neonates, but it is a bacterium, not an amoeba. **High-Yield Clinical Pearls for NEET-PG:** * **Clinical History:** Look for a history of swimming in warm stagnant water or ponds. * **CSF Findings:** Purulent CSF with high neutrophils (mimicking bacterial meningitis) but **negative Gram stain/culture**. * **Diagnosis:** Wet mount of CSF shows **motile trophozoites**. * **Drug of Choice:** Amphotericin B (often combined with Miltefosine). * **Morphology:** *Naegleria* has three stages (trophozoite, flagellate, and cyst), but only the **trophozoite** is found in human tissue.
Explanation: ### Explanation **1. Why Option A is the Correct Answer (The Exception):** In cases of **Amebic Liver Abscess (ALA)**, the intestinal phase of the infection has often resolved by the time the patient presents with hepatic symptoms. Consequently, stool microscopy for trophozoites or cysts is **negative in 60–90% of patients**. Therefore, stool examination is not essential nor reliable for clinical diagnosis. The gold standard for diagnosis involves a combination of **imaging (Ultrasound/CT)** and **serology (ELISA for antibodies)**, which is positive in over 90% of cases. **2. Analysis of Incorrect Options:** * **Option B (Mostly asymptomatic):** This refers to the general infection with *Entamoeba histolytica*. Approximately 90% of individuals infected with the parasite remain asymptomatic (luminal amebiasis), making this a true statement. * **Option C (More common in males):** ALA shows a striking male-to-female predilection (ratio of **7:1 to 10:1**). This is attributed to the protective effect of menstrual blood loss (lowering iron stores required by the parasite) and higher alcohol consumption among males. * **Option D (Rarely affects brain, eye, and skin):** While the liver is the most common site for extra-intestinal amebiasis, secondary spread to the brain, lungs, skin (Amebiasis cutis), and pericardium is documented but remains **rare**. **3. High-Yield Clinical Pearls for NEET-PG:** * **Pus Characteristics:** The aspirated pus from ALA is classically described as **"Anchovy Sauce"** appearance (chocolate brown, odorless, and sterile). * **Trophozoites location:** Trophozoites are found in the **abscess wall**, not the central necrotic pus. * **Treatment:** **Metronidazole** is the drug of choice, followed by a luminal amebicide (e.g., Diloxanide furoate) to eradicate the intestinal carrier state. * **Imaging:** ALA typically presents as a **solitary lesion** in the **right lobe** of the liver (due to the portal blood flow pattern).
Explanation: **Explanation:** **Echinococcus granulosus** (the dog tapeworm) is the causative agent of **Hydatid disease**. In humans (accidental intermediate hosts), the ingested eggs hatch into oncospheres that penetrate the intestinal wall and enter the portal circulation. While the **liver** is the most common site (approx. 70%), the **lungs** are the second most common site (approx. 20-25%) for the formation of slow-growing, fluid-filled **hydatid cysts**. These cysts are characterized by a three-layered wall (pericyst, ectocyst, and endocyst) and can cause symptoms like cough, chest pain, or hemoptysis. **Analysis of Incorrect Options:** * **Ascaris lumbricoides:** While it causes pulmonary symptoms during the larval migration phase (**Loeffler’s syndrome**), it results in transient eosinophilic infiltrates, not permanent or fluid-filled cysts. * **Toxocara canis:** Causes **Visceral Larva Migrans**. It leads to granulomatous lesions in the liver, lungs, or eyes, but does not form true hydatid-like cysts. * **Trypanosoma:** *T. cruzi* (Chagas disease) primarily affects the heart (myocarditis) and GI tract (mega-esophagus/colon), while *T. brucei* causes Sleeping Sickness. Neither is associated with lung cysts. **High-Yield NEET-PG Pearls:** * **Radiology:** Look for the **"Water-lily sign"** (Casoni’s sign) or "Camelot sign" on CXR, indicating a ruptured endocyst floating in the cyst fluid. * **Diagnosis:** Indirect Hemagglutination (IHA) or ELISA; **Casoni’s intradermal test** is now largely historical. * **Treatment:** Surgical removal is preferred. **PAIR** (Puncture, Aspiration, Injection, Re-aspiration) is a minimally invasive alternative. Medical management involves **Albendazole**. * **Risk:** Rupture of a lung cyst can lead to life-threatening **anaphylactic shock**.
Explanation: **Explanation:** The definitive identification of *Cryptosporidium parvum* relies on high sensitivity and specificity. While several methods exist, the **Direct Fluorescent Antibody (DFA) test** (Immunofluorescence) is considered the gold standard for diagnosis. 1. **Why Option B is correct:** Immunofluorescence (DFA) uses labeled monoclonal antibodies directed against the oocyst wall. It is significantly more sensitive (approaching 100%) and specific than conventional staining. It allows for the definitive identification of even a small number of oocysts, which might be missed by routine microscopy. 2. **Why other options are incorrect:** * **Option A (ELISA):** While useful for screening and epidemiological studies to detect fecal antigens, it is generally considered less sensitive than DFA and does not allow for the visualization of the morphology of the parasite. * **Option C (Demonstration of oocysts):** This refers to routine wet mounts. *Cryptosporidium* oocysts are small (4–6 µm) and transparent, making them extremely difficult to identify in unstained fecal samples. * **Option D (Auramine staining):** This is a screening tool. While fluorescent staining makes oocysts easier to spot than acid-fast stains, it is not as definitive as antibody-specific immunofluorescence. **High-Yield Clinical Pearls for NEET-PG:** * **Staining:** The classic morphological stain is the **Modified Ziehl-Neelsen (Acid-fast) stain**, where oocysts appear as red, spherical bodies against a blue background. * **Clinical Presentation:** It is a major cause of self-limiting diarrhea in immunocompetent individuals but causes **profuse, life-threatening watery diarrhea** in HIV/AIDS patients (CD4 count <200 cells/mm³). * **Treatment:** **Nitazoxanide** is the drug of choice in immunocompetent patients; HAART is the mainstay for HIV patients. * **Transmission:** Fecal-oral route; oocysts are highly resistant to chlorination.
Classification of Parasites
Practice Questions
Intestinal Protozoa
Practice Questions
Blood and Tissue Protozoa
Practice Questions
Malaria Parasites
Practice Questions
Leishmaniasis
Practice Questions
Intestinal Helminths: Nematodes
Practice Questions
Tissue Nematodes
Practice Questions
Trematodes
Practice Questions
Cestodes
Practice Questions
Ectoparasites
Practice Questions
Antiparasitic Drugs
Practice Questions
Laboratory Diagnosis of Parasitic Infections
Practice Questions
Get full access to all questions, explanations, and performance tracking.
Start For Free